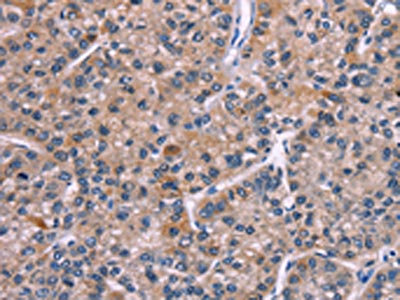

PIP5K1B Antibody
-
中文名稱:PIP5K1B兔多克隆抗體
-
貨號:CSB-PA137893
-
規(guī)格:¥1100
-
圖片:
-
The image on the left is immunohistochemistry of paraffin-embedded Human thyroid cancer tissue using CSB-PA137893(PIP5K1B Antibody) at dilution 1/30, on the right is treated with fusion protein. (Original magnification: ×200)
-
The image on the left is immunohistochemistry of paraffin-embedded Human liver cancer tissue using CSB-PA137893(PIP5K1B Antibody) at dilution 1/30, on the right is treated with fusion protein. (Original magnification: ×200)
-
-
其他:
產(chǎn)品詳情
-
Uniprot No.:
-
基因名:
-
別名:MSS 4 antibody; MSS4 antibody; Phosphatidylinositol 4 phosphate 5 kinase type 1 beta antibody; Phosphatidylinositol-4-phosphate 5-kinase type I beta antibody; Phosphatidylinositol-4-phosphate 5-kinase type-1 beta antibody; PI4P5K 1 beta antibody; PI51B_HUMAN antibody; PIP5K1-beta antibody; PIP5K1B antibody; PIP5KIbeta antibody; Pipk 5 beta antibody; Pipk 5b antibody; Protein STM 7 antibody; Protein STM-7 antibody; PtdIns(4)P-5-kinase 1 beta antibody; STM 7 antibody; STM7 antibody; STM7 LSB antibody; Type I phosphatidylinositol 4 phosphate 5 kinase beta antibody; Type I phosphatidylinositol-4-phosphate 5-kinase beta antibody
-
宿主:Rabbit
-
反應(yīng)種屬:Human,Mouse,Rat
-
免疫原:Fusion protein of Human PIP5K1B
-
免疫原種屬:Homo sapiens (Human)
-
標(biāo)記方式:Non-conjugated
-
抗體亞型:IgG
-
純化方式:Antigen affinity purification
-
濃度:It differs from different batches. Please contact us to confirm it.
-
保存緩沖液:-20°C, pH7.4 PBS, 0.05% NaN3, 40% Glycerol
-
產(chǎn)品提供形式:Liquid
-
應(yīng)用范圍:ELISA,IHC
-
推薦稀釋比:
Application Recommended Dilution ELISA 1:2000-1:5000 IHC 1:50-1:200 -
Protocols:
-
儲存條件:Upon receipt, store at -20°C or -80°C. Avoid repeated freeze.
-
貨期:Basically, we can dispatch the products out in 1-3 working days after receiving your orders. Delivery time maybe differs from different purchasing way or location, please kindly consult your local distributors for specific delivery time.
-
用途:For Research Use Only. Not for use in diagnostic or therapeutic procedures.
相關(guān)產(chǎn)品
靶點詳情
-
功能:Catalyzes the phosphorylation of phosphatidylinositol 4-phosphate (PtdIns(4)P/PI4P) to form phosphatidylinositol 4,5-bisphosphate (PtdIns(4,5)P2/PIP2), a lipid second messenger that regulates several cellular processes such as signal transduction, vesicle trafficking, actin cytoskeleton dynamics, cell adhesion, and cell motility. PtdIns(4,5)P2 can directly act as a second messenger or can be utilized as a precursor to generate other second messengers: inositol 1,4,5-trisphosphate (IP3), diacylglycerol (DAG) or phosphatidylinositol-3,4,5-trisphosphate (PtdIns(3,4,5)P3/PIP3). Mediates RAC1-dependent reorganization of actin filaments. Contributes to the activation of phospholipase PLD2. Together with PIP5K1A, is required, after stimulation by G-protein coupled receptors, for the synthesis of IP3 that will induce stable platelet adhesion.
-
基因功能參考文獻:
- Data indicate that type I phosphatidylinositol 4-phosphate 5-kinase PIP5KIbeta mutants whose dimerization was impaired showed a severe decrease in PI(4,5)P2 production and plasma membrane delocalization. PMID: 25713054
- Knockdown of PIP5K1B in fibroblasts reproduced abnormal actin cytoskeleton remodeling evidenced in Friedreich's ataxia patient cells. PMID: 23552101
- Results identify PIPKIbeta as a novel regulator of focal adhesion disassembly and suggest that PIPKIbeta spatially regulates beta1 integrin endocytosis at adhesion sites to control cell migration. PMID: 20624912
- Results identify an isoform-specific PDZ-binding motif in PIP5KIbeta, which confers specificity for PIP5KIbeta signaling at the uropod during leukocyte chemotaxis. PMID: 20442317
- findings show that the human type I phosphatidylinositol 4-phosphate 5-kinase isoform beta (PIPKIbeta) has a role in organizing signaling at the cell rear PMID: 18158329
- Syk-dependent phosphorylation of PIP5K1B is the dominant modification responsible for the decrease in cellular phosphatidylinositol 4,5-bisphosphate. PMID: 19553680
- Observational study and genome-wide association study of gene-disease association, gene-environment interaction, and pharmacogenomic / toxicogenomic. (HuGE Navigator) PMID: 19850283
顯示更多
收起更多
-
亞細胞定位:Cytoplasm, cytosol. Cell membrane. Endomembrane system.
-
組織特異性:Detected in heart, pancreas, brain, kidney, skeletal muscle and lung.
-
數(shù)據(jù)庫鏈接:
Most popular with customers
-
-
YWHAB Recombinant Monoclonal Antibody
Applications: ELISA, WB, IHC, IF, FC
Species Reactivity: Human, Mouse, Rat
-
Phospho-YAP1 (S127) Recombinant Monoclonal Antibody
Applications: ELISA, WB, IHC
Species Reactivity: Human
-
-
-
-
-